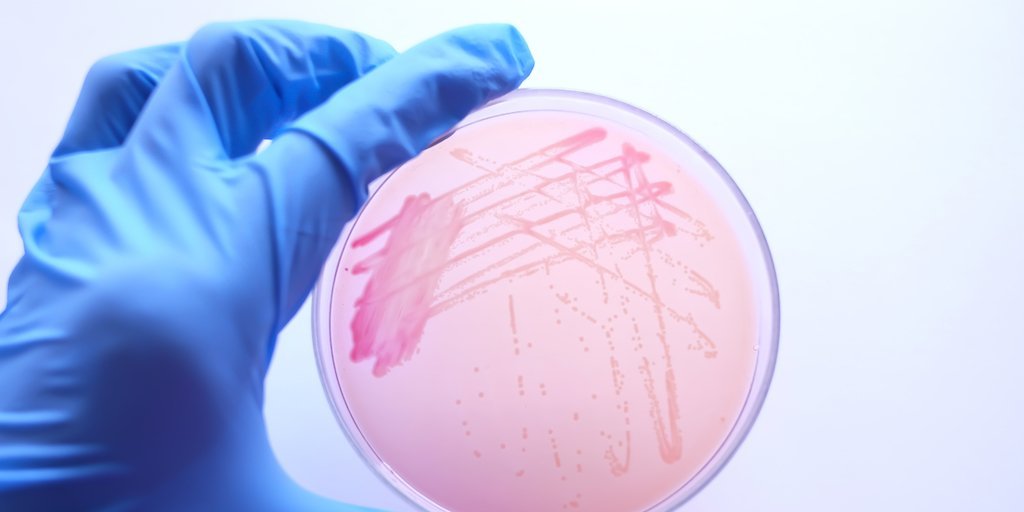

In Nov. EFSA BIOHAZ published findings on microbial hazards associated with water used in postharvest handling & processing of fruits, vegetables & herbs.
Recognizing challenges of manual processes, deployment of an automated solution like Novolyze EM simplifies sampling activities and enhances coordination.
Novolyze SMART Process Control is revolutionizing the industry by offering material savings in operational costs and efficiencies for rapid ROI.
Novolyze was recently honored with the prestigious Stratus Award for Cloud Computing, recognizing their groundbreaking SMART Process Control platform.
In a major development for food safety, CSTE recently decided to include Cronobacter sakazakii infections on the list of nationally notifiable conditions.
With recent steps taken by the USDA’s Food Safety Inspection Service (FSIS), change is on the horizon. What should a poultry processor’s next steps be?
The data to be collected during processing depends on the manufacturer’s specific challenges and objectives in setting up a smart process control platform.
Emma was an FSQA expert with leading US protein processors, whose insights helped support greater digitalization and more efficient food safety programs.
Data collection is a challenge. The food sector has difficulty ensuring consistent quality control measures and processes across its value chain.
Let’s delve into the details of the recent Sedgwick report that showed a 700 percent increase in the number of units recalled in 2022 compared to 2021.